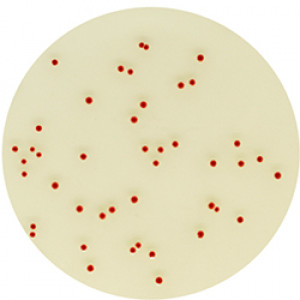

Performance
“Campylobacter bacteria are a major cause of foodborne diarrhoeal illness in humans and are the most common bacteria that cause gastroenteritis worldwide. In developed and developing countries, they cause more cases of diarrhoea than foodborne Salmonella. The high incidence of Campylobacter diarrhoea, as well as its duration and possible sequelae, makes it highly important from a socio-economic perspective. In developing countries, Campylobacter infections in children under the age of two years are especially frequent, sometimes resulting in death.”
World Health Organisation (WHO) – fact sheet N°255
Campylobacter spp. are fastidious bacteria that may be difficult to recover due to suboptimal specimen transport and/or storage conditions and lack of proper culture procedures. Several culture media formulations have been developed, some blood-based other including charcoal. Each of these media have shown to be a mediocre compromise between specificity and sensitivity.
Intended Use
CHROMagar™ Campylobacter is a selective chromogenic culture medium intended for use in the qualitative direct detection, differentiation and presumptive identification of thermotolerant Campylobacter. The test is performed with rectal swabs and stools, to aid in the diagnosis of Campylobacter infections. Results can be interpreted after 36-48 h of micro-aerophilic incubation at 42 °C.